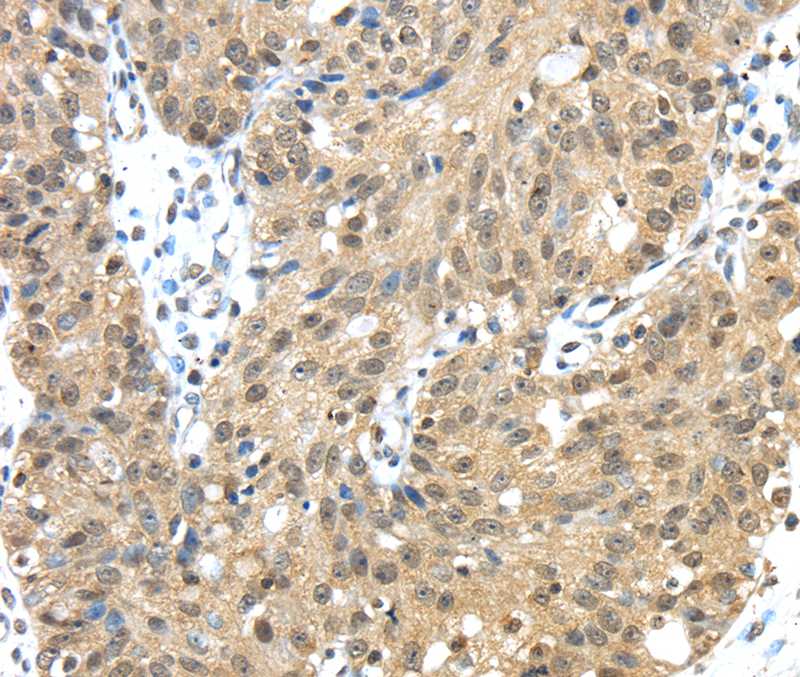
Anti-TMED3 Antibody

WB analysis of HepG2 cells using GTX46396 TMED3 antibody at 2.5microg/ml. Lane A : marker Lane B : HepG2 cells
TMED3 antibody, C-term
GTX46396
ApplicationsWestern Blot
Product group Antibodies
TargetTMED3
Overview
- SupplierGeneTex
- Product NameTMED3 antibody, C-term
- Delivery Days Customer9
- Application Supplier NoteWB: 0.2-2.5 ug/ml. *Optimal dilutions/concentrations should be determined by the researcher.Not tested in other applications.
- ApplicationsWestern Blot
- CertificationResearch Use Only
- ClonalityPolyclonal
- Concentration0.5-1 mg/ml
- ConjugateUnconjugated
- Gene ID23423
- Target nameTMED3
- Target descriptiontransmembrane p24 trafficking protein 3
- Target synonymsC15orf22, P24B, p24g4, p24gamma4, p26, transmembrane emp24 domain-containing protein 3, integral type I protein, membrane protein p24B, p24 family protein gamma-4, testis tissue sperm-binding protein Li 48e, transmembrane emp24 protein transport domain containing 3
- HostRabbit
- IsotypeIgG
- Protein IDQ9Y3Q3
- Protein NameTransmembrane emp24 domain-containing protein 3
- Storage Instruction-20°C or -80°C,2°C to 8°C
- UNSPSC12352203